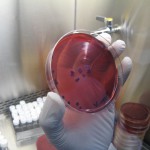

Tod aus dem Labor?
Das tödliche Bakterium Burkholderia Pseudomallei in einer Petrischale
Ein Film von John A. Kantara
Erstausstrahlung:
01.09.2008, um 21.30 Uhr
Wiederholung:
07.09.2008, um 16.00 Uhr
Notiz von Kantara´s Küchentisch….
Tod aus dem Labor?
Sieben Jahre ist es her, dass eine Anschlagserie fünf Menschen tötete, 17 verletzte und ungleich mehr Menschen in Angst und Schrecken versetzte: Todbringende Bakterien, die die Infektionskrankheit Anthrax, auch Milzbrand genannt, hervorrufen, wurden in normalen Briefen, mit der normalen Post an Journalisten und Regierungsbeamte verschickt. Der Bio-Kampfstoff kam heimlich, unverhofft und hinterhältig zu seinen Opfern.
Anfang August 2008 hat die US-Justiz in einer Indizienkette einen Angestellten eines Forschungslabors, das im Dienste der US-Regierung stand, als „einzig Verantwortlichen“ festgestellt.
Durch Militärforschung für Bio-Kampfstoffe und deren Abwehr sind in solchen Laboren gefährlichere, künstliche Varianten bekannter Erreger entstanden. Viele dieser Experimente an solchen „Menschenkillern“ sind normale Versuche an amerikanischen und europäischen Universitäten. Denn, so das Argument, der Rechtsstaat müsse sich vor potenziellen Bio-Gefahren schützen. Doch seit den Anschlägen vor sieben Jahren hat es weltweit keinen weiteren Terrorangriff mit Bio-Waffen gegeben: Alles also nur Panikmache? Erst durch Forschung für Bio-Kampfstoffe und deren Abwehr sind in den Laboren gefährlichere Varianten bekannter Erreger entstanden.